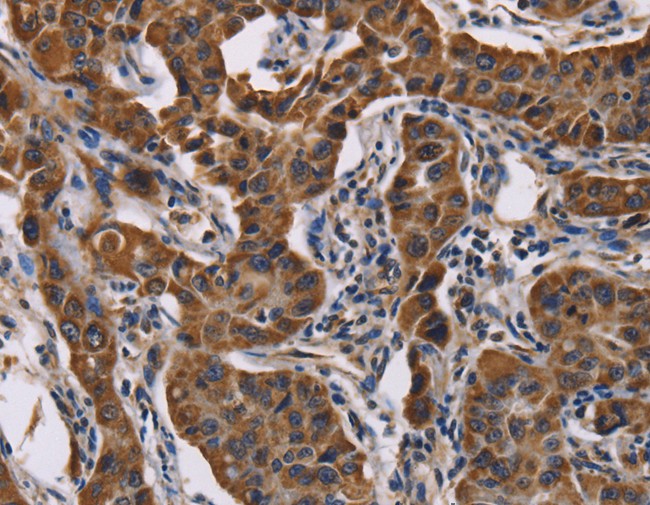
product-image-AAA169580_IHC13.jpg

Reactivity
Human
Samples
cell culture supernatants, serum and plasma (heparin, EDTA)
Assay Range
93.7pg/ml-6,000pg/ml
Sensitivity
<47pg/ml
Capture antibody and Detection antibody
a polyclonal antibody from goat|a biotinylated polyclonal antibody from goat
Immunogen
Expression system for standard: CHO; Immunogen sequence: F31-V992
Anticoagulant
heparin or EDTA
Cross Reactivity
There is no detectable cross-reactivity with other relevant proteins.
Applicable Applications for CD51 elisa kit
ELISA
Kit Components
Description/Quantity
Pre-coated 96-well strip microplate/1
Standard/2 vials, 10 ng/tube
Biotinylated antibody (100x)/100ul
Avidin-Biotin-Peroxidase Complex (100x)/100ul
Sample Diluent/30ml
Antibody Diluent/12ml
Avidin-Biotin-Peroxidase Diluent/12ml
Color Developing Reagent (TMB)/10ml
Stop Solution/10ml
Wash Buffer (25x)/20ml
Adhesive plate sealers/4
Pre-coated 96-well strip microplate/1
Standard/2 vials, 10 ng/tube
Biotinylated antibody (100x)/100ul
Avidin-Biotin-Peroxidase Complex (100x)/100ul
Sample Diluent/30ml
Antibody Diluent/12ml
Avidin-Biotin-Peroxidase Diluent/12ml
Color Developing Reagent (TMB)/10ml
Stop Solution/10ml
Wash Buffer (25x)/20ml
Adhesive plate sealers/4
Materials Required But Not Provided
Microplate Reader capable of reading absorbance at 450nm.
Incubator.
Automated plate washer (optional).
Pipettes and pipette tips capable of precisely dispensing 0.5ul through 1ml volumes of aqueous solutions.
Multichannel pipettes are recommended for large amount of samples.
Deionized or distilled water.
500ml graduated cylinders.
Test tubes for dilution.
Incubator.
Automated plate washer (optional).
Pipettes and pipette tips capable of precisely dispensing 0.5ul through 1ml volumes of aqueous solutions.
Multichannel pipettes are recommended for large amount of samples.
Deionized or distilled water.
500ml graduated cylinders.
Test tubes for dilution.
Sample Data
| Concentration(pg/ml) | 0 | 93.7 | 187.5 | 375 | 750 | 1,500 | 3,000 | 6,000 |
| O.D. | 0.031 | 0.069 | 0.143 | 0.315 | 0.692 | 0.926 | 1.425 | 2.054 |
Intra Assay Consistency & Inter Assay Consistency
| Intra-Assay Precision | Inter-Assay Precision | |||||
|---|---|---|---|---|---|---|
| Sample | 1 | 2 | 3 | 1 | 2 | 3 |
| n | 16 | 16 | 16 | 24 | 24 | 24 |
| Mean(pg/ml) | 179 | 236 | 2233 | 108 | 249 | 2866 |
| Standard deviation | 6.01 | 14.18 | 86.64 | 4.36 | 19 | 95.15 |
| CV(%) | 3.4% | 6% | 3.9% | 4% | 7.6% | 3.3% |
Reproducibility
| Lots | Lot 1 (pg/ml) | Lot 2 (pg/ml) | Lot 3 (pg/ml) | Lot 4 (pg/ml) | Mean (pg/ml) | Standard Deviation | CV (%) |
|---|---|---|---|---|---|---|---|
| Sample 1 | 179 | 151 | 95 | 120 | 136 | 3.15 | 2.3% |
| Sample 2 | 236 | 204 | 241 | 308 | 247 | 12.81 | 5.2% |
| Sample 3 | 2233 | 1878 | 2332 | 2092 | 2134 | 93.24 | 4.4% |
Preparation and Storage
Store at 4 degree C for 6 months, at -20 degree C for 12 months. Avoid multiple freeze-thaw cycles (Ships with gel ice, can store for up to 3 days in room temperature. Freeze upon receiving.)
Related Product Information for CD51 elisa kit
The brand Picokine indicates this is a premium quality ELISA kit. Each Picokine kit delivers precise quantification, high sensitivity, and excellent reproducibility. Only our most reliable and effective kits qualify as Picokine, guaranteeing top-tier results for your assays.
Product Categories/Family for CD51 elisa kit
NCBI and Uniprot Product Information
NCBI GI #
NCBI GeneID
NCBI Accession #
NCBI GenBank Nucleotide #
Molecular Weight
116,038 Da
NCBI Official Full Name
integrin alpha-V isoform 2
NCBI Official Synonym Full Names
integrin, alpha V
NCBI Official Symbol
ITGAV
NCBI Official Synonym Symbols
CD51; MSK8; VNRA; VTNR
NCBI Protein Information
integrin alpha-V; integrin alphaVbeta3; vitronectin receptor subunit alpha; antigen identified by monoclonal antibody L230; integrin, alpha V (vitronectin receptor, alpha polypeptide, antigen CD51)
UniProt Protein Name
Integrin alpha-V
UniProt Gene Name
ITGAV
UniProt Synonym Gene Names
MSK8; VNRA
UniProt Entry Name
ITAV_HUMAN
Customer Reviews
Loading reviews...
Share Your Experience
Similar Products
Product Notes
The Human CD51 itgav (Catalog #AAA127975) is an ELISA Kit and is intended for research purposes only. The product is available for immediate purchase. The AAA127975 ELISA Kit recognizes Human CD51. AAA Biotech's CD51 can be used in a range of immunoassay formats including, but not limited to, ELISA. Researchers should empirically determine the suitability of the CD51 itgav for an application not listed in the data sheet. Researchers commonly develop new applications and it is an integral, important part of the investigative research process. It is sometimes possible for the material contained within the vial of "CD51, ELISA Kit" to become dispersed throughout the inside of the vial, particularly around the seal of said vial, during shipment and storage. We always suggest centrifuging these vials to consolidate all of the liquid away from the lid and to the bottom of the vial prior to opening. Please be advised that certain products may require dry ice for shipping and that, if this is the case, an additional dry ice fee may also be required.Precautions
All products in the AAA Biotech catalog are strictly for research-use only, and are absolutely not suitable for use in any sort of medical, therapeutic, prophylactic, in-vivo, or diagnostic capacity. By purchasing a product from AAA Biotech, you are explicitly certifying that said products will be properly tested and used in line with industry standard. AAA Biotech and its authorized distribution partners reserve the right to refuse to fulfill any order if we have any indication that a purchaser may be intending to use a product outside of our accepted criteria.Disclaimer
Though we do strive to guarantee the information represented in this datasheet, AAA Biotech cannot be held responsible for any oversights or imprecisions. AAA Biotech reserves the right to adjust any aspect of this datasheet at any time and without notice. It is the responsibility of the customer to inform AAA Biotech of any product performance issues observed or experienced within 30 days of receipt of said product. To see additional details on this or any of our other policies, please see our Terms & Conditions page.Item has been added to Shopping Cart
If you are ready to order, navigate to Shopping Cart and get ready to checkout.